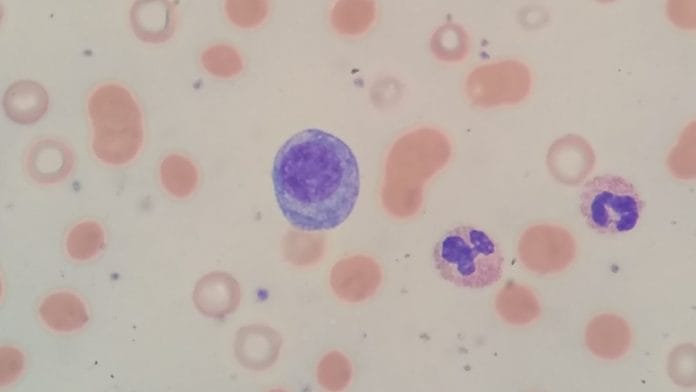
Peripheral blood smear showing findings associated with multiple myeloma | Representational image | Commons

New Delhi: US pharma giant Bristol Myers Squibb along with its partner 2seventy bio has announced that it has successfully tested in humans a type of therapy for multiple myeloma that is based on re-engineered human T cells developed from stem cells in the bone marrow.
Multiple myeloma is cancer of the plasma cells in blood.
The therapy — called ‘Abecma’ (idecabtagene vicleucel) — shows significantly better results than standard therapies used against relapsed multiple myeloma, the company has claimed. The findings were the result of KarMMA-3 — a phase 3, global, open-label study, and the first randomised clinical trial to evaluate a ‘CAR T cell therapy’ in multiple myeloma.
The study, according to Bristol Myers Squibb and 2seventy bio, evaluated Abecma compared to standard combination regimens used to treat adults with multiple myeloma that has relapsed after two to four prior lines of therapy and was unresponsive to the last regimen.
CAR T or chimeric antigen receptor T cell is a re-engineered human T cell that is removed from the body of the cancer patient and modified in the laboratory to recognise and attack the specific kind of cancer that a patient is afflicted with. It is aimed at stimulating the patient’s own immune system to act more efficiently and is the final form that cancer immunotherapy takes.
In 2018, the Nobel Prize for medicine was given to immunologist Jim Allison who had devised a way to treat cancer by targeting the immune system to work more efficiently rather than targeting the tumour.
In a statement issued earlier this week, Bristol Myers Squibb and 2seventy bio said that “pre-specified interim analysis” conducted through an independent review committee showed that KarMMa-3 met its primary endpoint of demonstrating a statistically significant improvement in progression-free survival — the duration during and after cancer treatment that a patient lives with the disease without it getting worse.
The statement further said that treatment with Abecma “showed an improvement in the key secondary endpoint of overall response rate compared to standard regimens,” adding that follow-up for overall survival, a key secondary endpoint, remains ongoing.
Also Read: 175 dogs guard Assam’s pig heart doctor who bangs desk to speak. Patients still lining up
Abecma gets approval in the US
According to the press statement, Abecma is “the first-in-class B-cell maturation antigen (BCMA)-directed CAR T cell immunotherapy” approved in the US for treatment of adult patients “with relapsed or refractory multiple myeloma after four or more prior lines of therapy, including an immunomodulatory agent, a proteasome inhibitor, and an anti-CD38 monoclonal antibody”.
Traditionally, in cancer immunotherapies, trial endpoints deal with criteria like lack of progression and quality of life rather than remission as the latter is a tougher ask.
The trial found some common side effects in patients who receive Abecma, including cytokine release syndrome (CRS) — an acute systemic inflammatory syndrome — experienced by 85 per cent of the patients, while other infections were noted in the case of 70 per cent of the patients.
Results from the KarMMa-3 study clearly demonstrate the clinical benefit of using a CAR T cell therapy in the earlier stages of multiple myeloma treatment paradigm, said Anne Kerber, senior vice president and head of cell therapy development, Bristol Myers Squibb, according to the statement.
“This data reinforces our commitment to unlocking the full potential of cell therapy as we strive to build on the company’s heritage of innovation in blood cancers and transform patients’ lives through science,” Kerber added.
Steve Bernstein, M.D., chief medical officer, 2seventy bio, said these results help advance the company’s efforts to make Abecma available for earlier lines of treatment for patients.
He added that the company is looking forward to discussing these results with regulatory authorities.
(Edited by Amrtansh Arora)
Also Read: Fujifilm launches AI-powered health centre in Gurugram that can screen for 10 types of cancer